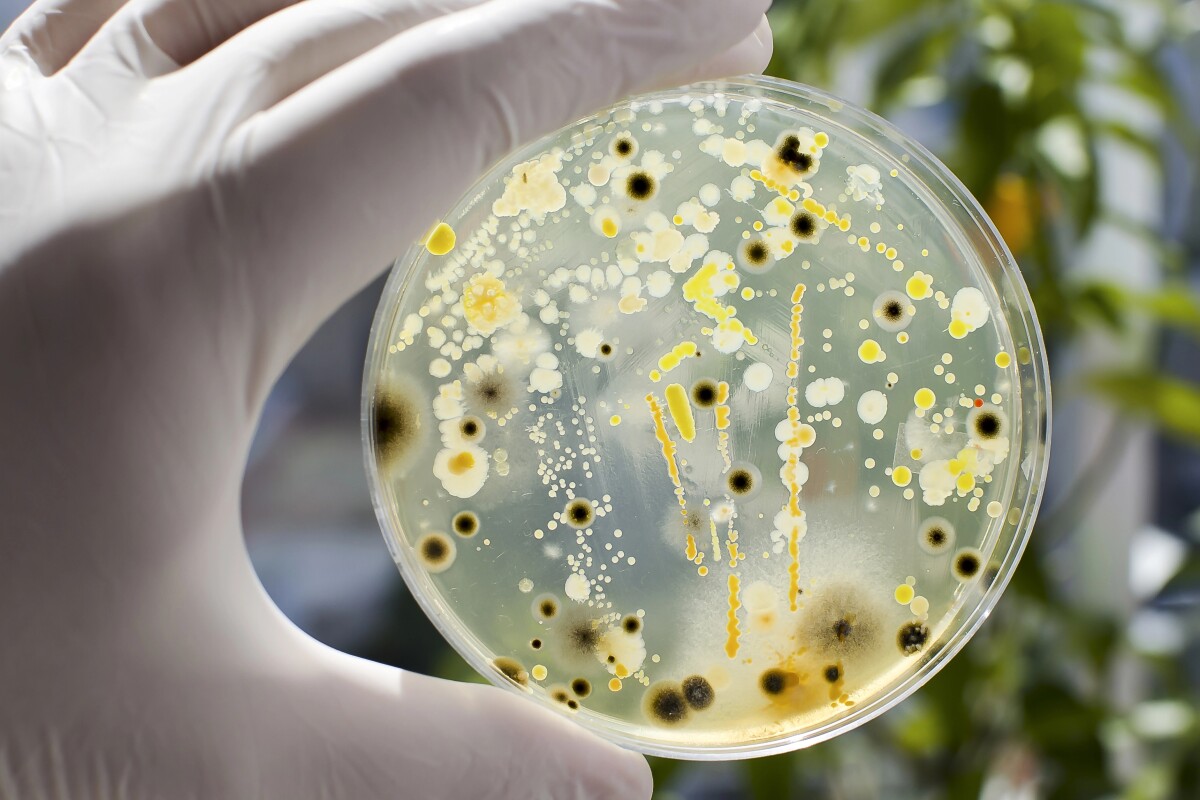
27 oral microbes drive 250% rise in pancreatic cancer risk

Happy Friday! It's Abhimanyu again, and I want to thank you for bearing with us as we work out the kinks with its new newsletter system – and for your feedback to help us improve. It'll only get better, promise!
I'm still trying to wrap my head around David's story about a solid-fueled ramjet that GE Aerospace is testing, as it enables an F-14 Starfighter to hit Mach 2.2, which is like 1,688 mph. Pretty sure that qualifies as rocket science.
As petrolheads, Utkarsh and I are always chomping at the bit to cover the latest in motorcycles, and he beat me to the punch yesterday with Honda's news about its gorgeous, classically styled CB500 Super Four. No biggie – I got to spend some time learning about how mining trucks could soon ditch their enormously expensive and wasteful rubber tires.
Dive into all that and the rest – and reply to this email if you've got feedback on our newsletter, or tips on more stuff we should cover!

GE Aerospace flies hypersonic engine with no moving parts
by David Szondy
What has zero moving parts, yet can blast an aerial vehicle to velocities beyond Mach 5? The answer is the recently flight-tested Atmospheric Test of Launched Airbreathing System (ATLAS) powered by a new solid-fueled ramjet built by GE Aerospace.
Today’s highlights

Surprise, surprise: Honda has quietly revealed the CB500 Super Four
by Utkarsh Sood
Honda has sent motorcycle enthusiasts into a state of frenzy by revealing the CB500 Super Four retro standard and CBR500R Four sportbike at this year's CIMAMotor show in Chongqing, China. Both models are scheduled to launch in early 2026.

Durable steel wheels could replace rubber tires on mining vehicles
by Abhimanyu Ghoshal
For nearly a decade, a Phoenix, Arizona-based outfit has been working on a smart replacement for the giant rubber tires that go on heavy mining vehicles. After rigorous testing, GACW's steel wheels are rolling towards a commercial launch this year.
Special promotion for New Atlas readers

Office 2021 + Windows 11 Pro = productivity unlocked for $55
Upgrade your PC with two Microsoft essentials in one bundle: Office Pro 2021 and Windows 11 Pro—lifetime licenses, a one-time $54.97 payment, and productivity forever.
More stories
27 oral microbes drive 250% rise in pancreatic cancer risk
For the first time, scientists have identified 27 bacteria and fungi in our mouth that contribute to pancreatic cancer. Collectively, carrying all of these “bad” microbes increases cancer risk by 250% – 3.5 times higher than in the general population.

Two-person Overnighter goes all in on travel-friendly tiny living
As its name suggests, the Overnighter by Nordic & Spruce isn't designed for large families and long stays. Instead, it offers an affordable and attractive tiny house that's a good fit for regular travel.

Review: Maono Wave T5 wireless microphone punches above its weight
Whether a content creator or a casual recording enthusiast, the Maono Wave T5 wireless mic ticks a lot of boxes without breaking the bank. Capture clean audio at home or on-the-go, with functionality and quality that belies its $89.99 starting price.

Architects reveal new model for urban living where desert meets forest
A new landmark has opened in Dubai that brings together desert architecture and forest living. The Ghaf Woods Experience Centre serves as an introduction to what's being described as the city’s first forest-integrated residential community.

Utterly adorable 530-lb micro-camping pod airs up into tiny-tent abode
The all-new Urbanoid Booba is an impossibly cute, tiny acorn of a trailer designed to provide a stylish, carefree way of instantly escaping the urban grind. The towable clamshell unfolds and inflates into a cozy base camp in a matter of minutes.

Dumped World War munitions and sunken ships serve a wild new purpose
Old Nazi warheads and US warships have been reclaimed by a new army of diverse marine life, as scientists for the first time uncover how nature has made use of the munitions and fleets that ended up dumped in waterways during the two world conflicts.

Berra tiny house doubles down on superb timber craftsmanship
Woodworking specialist Madeiguincho recently completed another of its eye-catching timber tiny houses. Named Berra, the dwelling showcases the firm's expertise with wood and provides a compact, light-filled home for a small family.
Get your next issue ad-free – and support our work: join New Atlas Plus!
